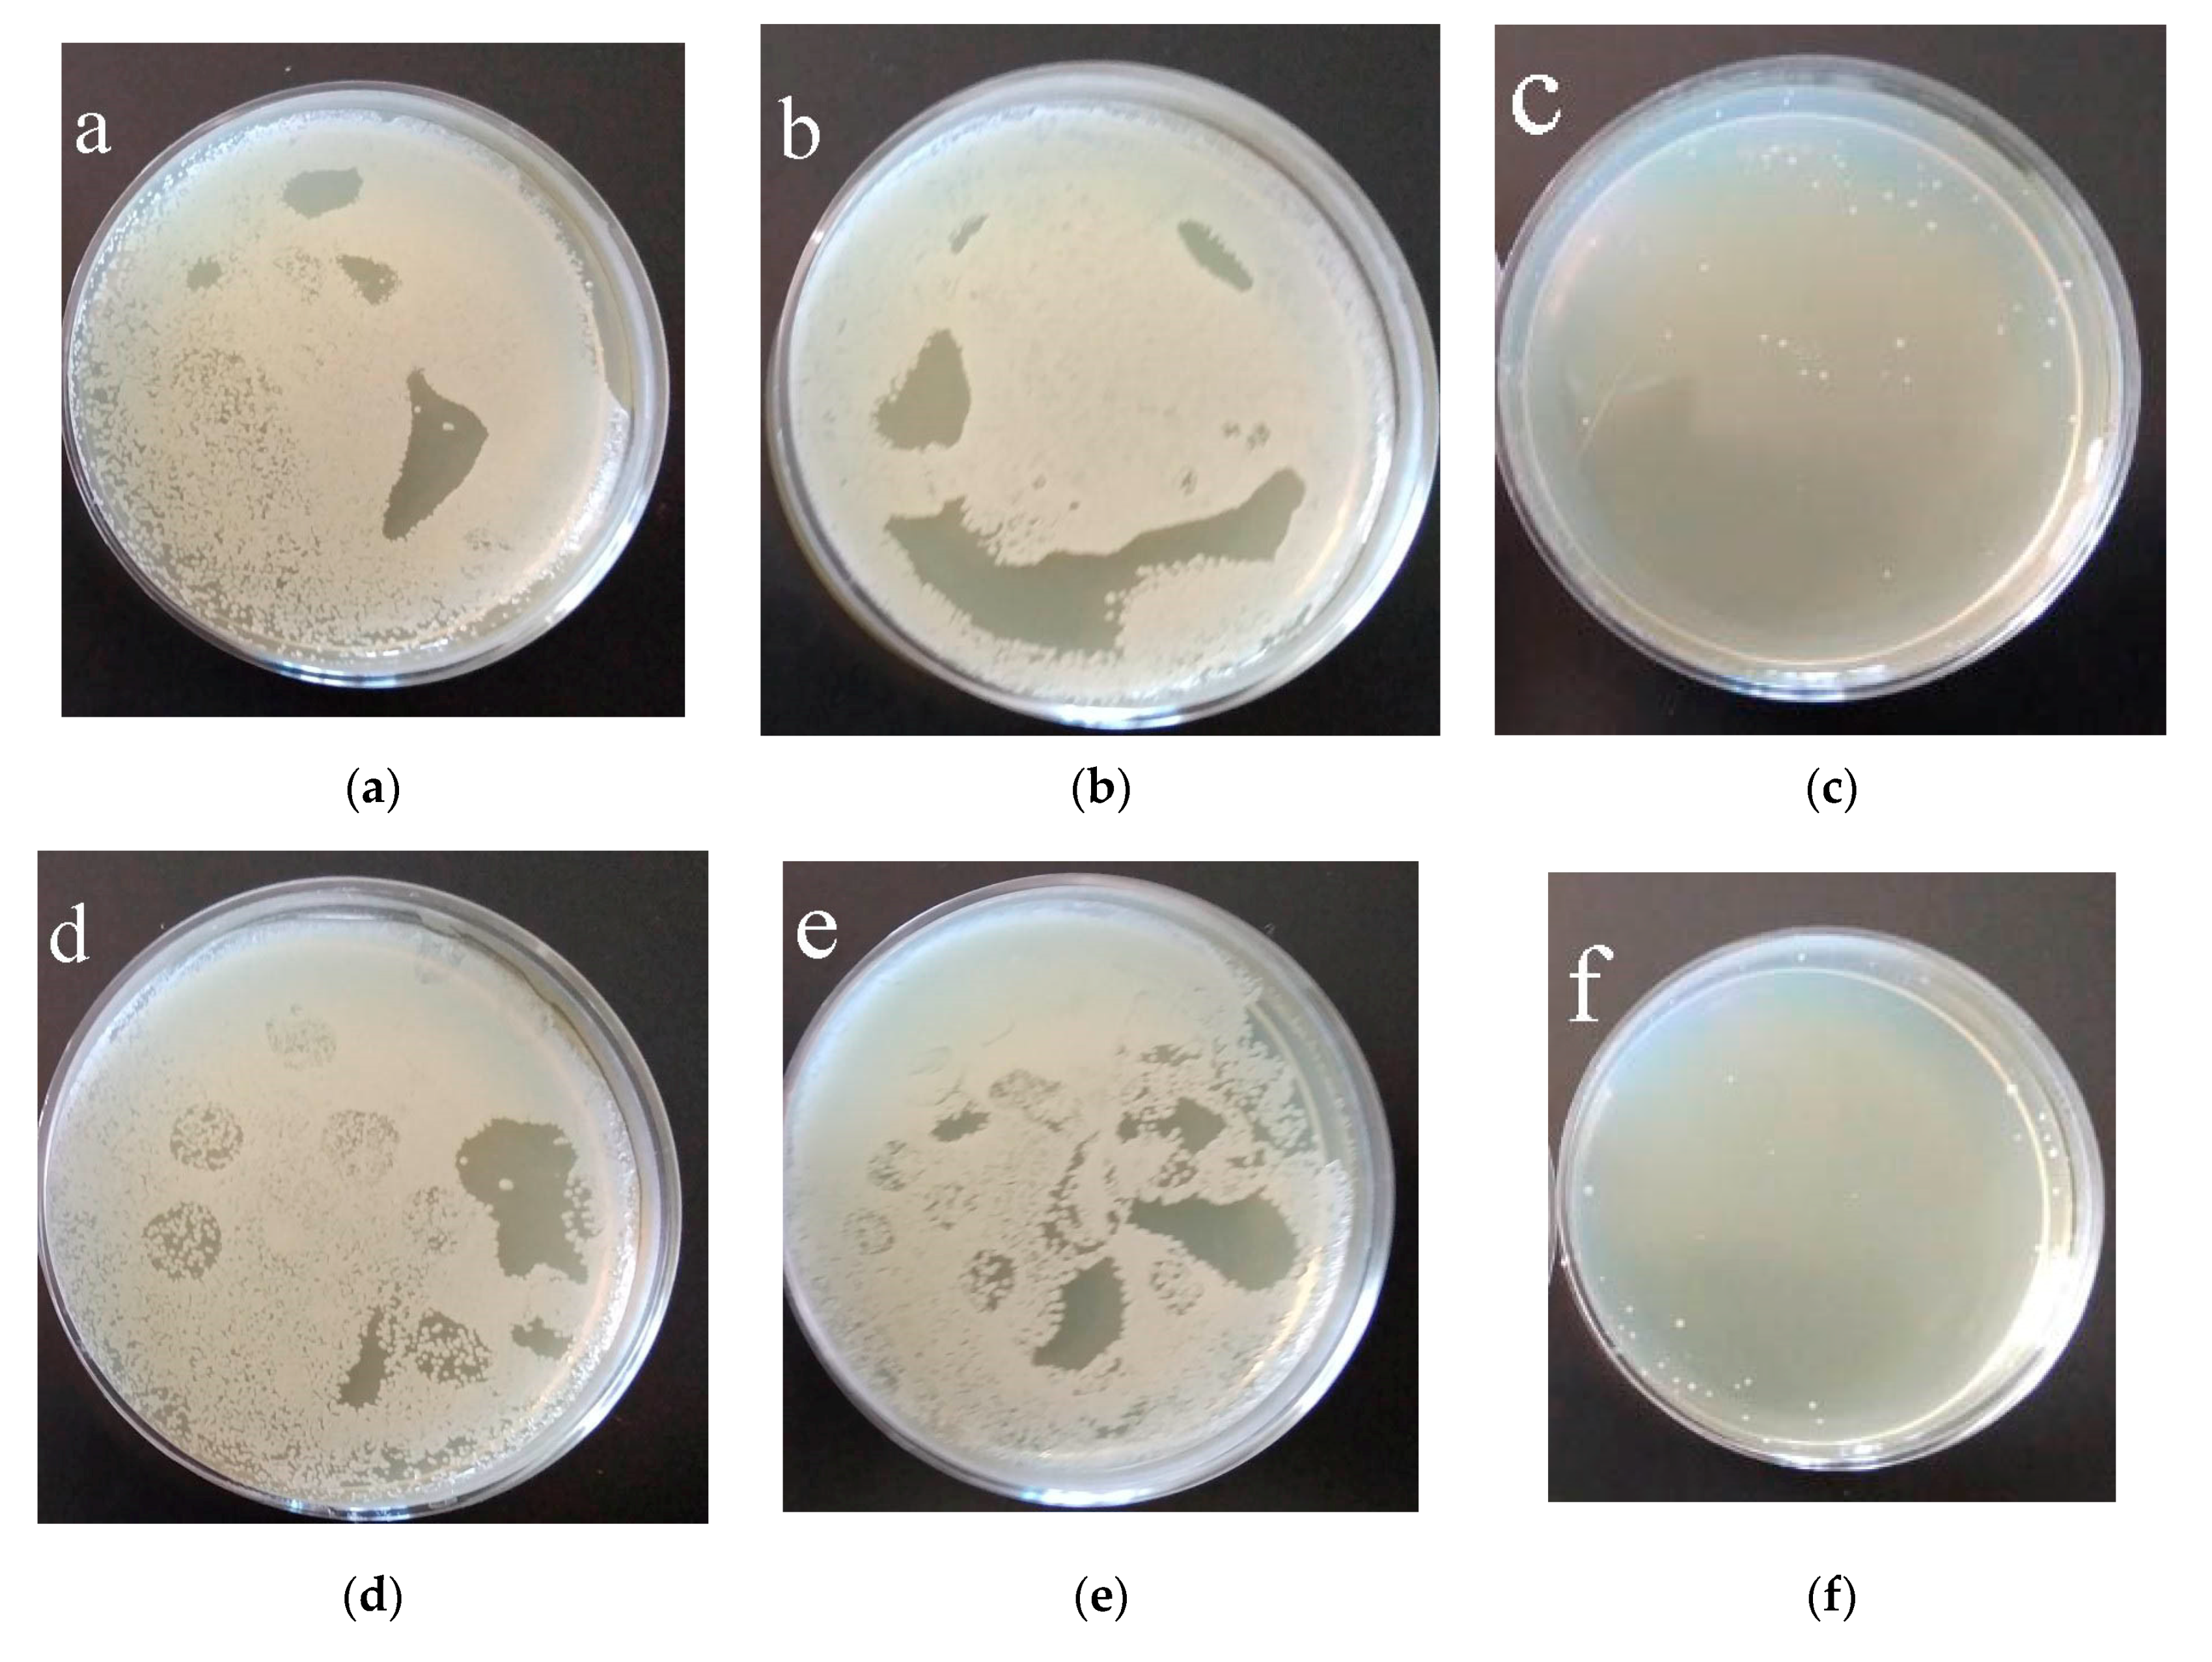
Coatings 13 01921 g012

Antibacterial Calcium Phosphate Coatings with Zinc Oxide Nanoparticles
Abstract
:1. Introduction
2. Materials and Methods
2.1. Sample Characterization and MAO Preparation
2.2. Investigation of Biological Properties
3. Results and Discussion
3.1. Morphology of the C-P Coatings
3.2. Elemental and Phase Composition of Functionalized Coatings
3.3. Electrical Properties of Modified Coatings
3.4. Electrochemical Properties of Modified Coatings
3.5. Biological Properties of Modified Coatings
4. Conclusions
Author Contributions
Funding
Institutional Review Board Statement
Informed Consent Statement
Data Availability Statement
Acknowledgments
Conflicts of Interest
References
- Mitra, I.; Bose, S.; Dernell, W.S.; Dasgupta, N.; Eckstrand, C.; Herrick, J.; Yaszemski, M.J.; Goodman, S.B.; Bandyopadhyay, A. 3D Printing in Alloy Design to Improve Biocompatibility in Metallic Implants. Mater. Today 2021, 45, 20–34. [Google Scholar] [CrossRef] [PubMed]
- Natarajan, D.; Ye, Z.; Wang, L.; Ge, L.; Pathak, J.L. Rare Earth Smart Nanomaterials for Bone Tissue Engineering and Implantology: Advances, Challenges, and Prospects. Bioeng. Transl. Med. 2022, 7, e10262. [Google Scholar] [CrossRef]
- Teo, A.J.T.; Mishra, A.; Park, I.; Kim, Y.-J.; Park, W.-T.; Yoon, Y.-J. Polymeric Biomaterials for Medical Implants and Devices. ACS Biomater. Sci. Eng. 2016, 2, 454–472. [Google Scholar] [CrossRef]
- Fiume, E.; Magnaterra, G.; Rahdar, A.; Verné, E.; Baino, F. Hydroxyapatite for Biomedical Applications: A Short Overview. Ceramics 2021, 4, 542–563. [Google Scholar] [CrossRef]
- Foster, A.L.; Moriarty, T.F.; Zalavras, C.; Morgenstern, M.; Jaiprakash, A.; Crawford, R.; Burch, M.-A.; Boot, W.; Tetsworth, K.; Miclau, T.; et al. The Influence of Biomechanical Stability on Bone Healing and Fracture-Related Infection: The Legacy of Stephan Perren. Injury 2021, 52, 43–52. [Google Scholar] [CrossRef] [PubMed]
- Joshi, T.; Sharma, R.; Kumar Mittal, V.; Gupta, V. Comparative Investigation and Analysis of Hip Prosthesis for Different Bio-Compatible Alloys. Mater. Today Proc. 2021, 43, 105–111. [Google Scholar] [CrossRef]
- Raza, A.; Deen, K.M.; Asselin, E.; Haider, W. TK Diagrams to Determine the Impact of PH Variation on 3D Printed CoCr Alloy Implant Corrosion. J. Electroanal. Chem. 2023, 929, 117087. [Google Scholar] [CrossRef]
- Perumal, G.; Grewal, H.S.; Arora, H.S. Enhanced Durability, Bio-Activity and Corrosion Resistance of Stainless Steel through Severe Surface Deformation. Colloids Surf. B Biointerfaces 2020, 194, 111197. [Google Scholar] [CrossRef] [PubMed]
- Huang, H.-L.; Tsai, M.-T.; Yang, Y.-J.; Hsu, J.-T.; Chang, Y.-Y. Mechanical, Antibacterial and Cytotoxic Characteristics of Nanolayered TiNb–Zr–Ta and Nitrogen-Doped TiNb–Zr–Ta Coatings. Mater. Chem. Phys. 2023, 309, 128437. [Google Scholar] [CrossRef]
- Walsh, F.C.; Low, C.T.J.; Wood, R.J.K.; Stevens, K.T.; Archer, J.; Poeton, A.R.; Ryder, A. Plasma Electrolytic Oxidation (PEO) for Production of Anodised Coatings on Lightweight Metal (Al, Mg, Ti) Alloys. Trans. IMF 2009, 87, 122–135. [Google Scholar] [CrossRef]
- Falisi, G.; Foffo, G.; Severino, M.; Di Paolo, C.; Bianchi, S.; Bernardi, S.; Pietropaoli, D.; Rastelli, S.; Gatto, R.; Botticelli, G. SEM-EDX Analysis of Metal Particles Deposition from Surgical Burs after Implant Guided Surgery Procedures. Coatings 2022, 12, 240. [Google Scholar] [CrossRef]
- Chebodaeva, V.; Sedelnikova, M.; Kashin, A.; Bakina, O.; Khlusov, I.; Zharin, A.; Egorkin, V.; Vyaliy, I.; Sharkeev, Y. Structure and Electrical Potential of Calcium Phosphate Coatings Modified with Aluminum Oxyhydroxide Nanoparticles. Lett. Mater. 2022, 12, 336–342. [Google Scholar] [CrossRef]
- Kashin, A.D.; Sedelnikova, M.B.; Chebodaeva, V.V.; Uvarkin, P.V.; Luginin, N.A.; Dvilis, E.S.; Kazmina, O.V.; Sharkeev, Y.P.; Khlusov, I.A.; Miller, A.A.; et al. Diatomite-Based Ceramic Biocoating for Magnesium Implants. Ceram. Int. 2022, 48, 28059–28071. [Google Scholar] [CrossRef]
- Lou, B.-S.; Lin, Y.-Y.; Tseng, C.-M.; Lu, Y.-C.; Duh, J.-G.; Lee, J.-W. Plasma Electrolytic Oxidation Coatings on AZ31 Magnesium Alloys with Si3N4 Nanoparticle Additives. Surf. Coat. Technol. 2017, 332, 358–367. [Google Scholar] [CrossRef]
- Nadimi, M.; Dehghanian, C. Incorporation of ZnO–ZrO2 Nanoparticles into TiO2 Coatings Obtained by PEO on Ti–6Al–4V Substrate and Evaluation of Its Corrosion Behavior, Microstructural and Antibacterial Effects Exposed to SBF Solution. Ceram. Int. 2021, 47, 33413–33425. [Google Scholar] [CrossRef]
- Mashtalyar, D.V.; Imshinetskiy, I.M.; Nadaraia, K.V.; Gnedenkov, A.S.; Suchkov, S.N.; Opra, D.P.; Pustovalov, E.V.; Yu Ustinov, A.; Sinebryukhov, S.L.; Gnedenkov, S.V. Effect of TiO2 Nanoparticles on the Photocatalytic Properties of PEO Coatings on Mg Alloy. J. Magnes. Alloys 2023, 11, 735–752. [Google Scholar] [CrossRef]
- Sedelnikova, M.B.; Komarova, E.G.; Sharkeev, Y.P.; Chebodaeva, V.V.; Tolkacheva, T.V.; Kondranova, A.M.; Zakharenko, A.M.; Bakina, O.V. Effect of the Porosity, Roughness, Wettability, and Charge of Micro-Arc Coatings on the Efficiency of Doxorubicin Delivery and Suppression of Cancer Cells. Coatings 2020, 10, 664. [Google Scholar] [CrossRef]
- Allenstein, U.; Ma, Y.; Arabi-Hashemi, A.; Zink, M.; Mayr, S.G. Fe–Pd Based Ferromagnetic Shape Memory Actuators for Medical Applications: Biocompatibility, Effect of Surface Roughness and Protein Coatings. Acta Biomater. 2013, 9, 5845–5853. [Google Scholar] [CrossRef]
- Zhang, J.; Guan, Y.; Lin, W.; Gu, X. Enhanced Mechanical Properties and Biocompatibility of Mg-Gd-Ca Alloy by Laser Surface Processing. Surf. Coat. Technol. 2019, 362, 176–184. [Google Scholar] [CrossRef]
- Rajan, S.T.; Das, M.; Arockiarajan, A. In Vitro Assessment of Corrosion Resistance and Biocompatibility of Tantalum-Niobium Oxide Surface-Functionalized Mg Alloy. Mater. Chem. Phys. 2023, 301, 127560. [Google Scholar] [CrossRef]
- Zhang, R.F.; Qiao, L.P.; Qu, B.; Zhang, S.F.; Chang, W.H.; Xiang, J.H. Biocompatibility of Micro-Arc Oxidation Coatings Developed on Ti6Al4V Alloy in a Solution Containing Organic Phosphate. Mater. Lett. 2015, 153, 77–80. [Google Scholar] [CrossRef]
- Kravchenko, I.N.; Kolomeichenko, A.V.; Sharifullin, S.N.; Kuznetsov, Y.A.; Baranov, Y.N.; Glinsky, M.A.; Kolomeichenko, A.A. Application of Nanostructured Coatings by Plasma Spraying. J. Phys. Conf. Ser. 2018, 1058, 012046. [Google Scholar] [CrossRef]
- Barati Darband, G.; Aliofkhazraei, M.; Hamghalam, P.; Valizade, N. Plasma Electrolytic Oxidation of Magnesium and Its Alloys: Mechanism, Properties and Applications. J. Magnes. Alloys 2017, 5, 74–132. [Google Scholar] [CrossRef]
- Chebodaeva, V.V.; Sedelnikova, M.B.; Bakina, O.V.; Miller, A.A.; Khimich, M.A.; Golohvast, K.S.; Zaharenko, A.M.; Sharkeev, Y.P. Effect of Aluminium Oxyhydroxide Nanoparticles on the Structure and Properties of the Calcium Phosphate Coatings. Surf. Interfaces 2022, 31, 101996. [Google Scholar] [CrossRef]
- Yao, T.; Chen, J.; Wang, Z.; Zhai, J.; Li, Y.; Xing, J.; Hu, S.; Tan, G.; Qi, S.; Chang, Y.; et al. The Antibacterial Effect of Potassium-Sodium Niobate Ceramics Based on Controlling Piezoelectric Properties. Colloids Surf. B Biointerfaces 2019, 175, 463–468. [Google Scholar] [CrossRef]
- Metwally, S.; Stachewicz, U. Surface Potential and Charges Impact on Cell Responses on Biomaterials Interfaces for Medical Applications. Mater. Sci. Eng. C 2019, 104, 109883. [Google Scholar] [CrossRef] [PubMed]
- Lozhkomoev, A.S.; Bakina, O.V.; Pervikov, A.V.; Kazantsev, S.O.; Glazkova, E.A. Synthesis of CuO–ZnO Composite Nanoparticles by Electrical Explosion of Wires and Their Antibacterial Activities. J. Mater. Sci. Mater. Electron. 2019, 30, 13209–13216. [Google Scholar] [CrossRef]
- Kizalaite, A.; Grigoraviciute-Puroniene, I.; Asuigui, D.R.C.; Stoll, S.L.; Cho, S.H.; Sekino, T.; Kareiva, A.; Zarkov, A. Dissolution–Precipitation Synthesis and Characterization of Zinc Whitlockite with Variable Metal Content. ACS Biomater. Sci. Eng. 2021, 7, 3586–3593. [Google Scholar] [CrossRef] [PubMed]
- Ali, A.; Phull, A.-R.; Zia, M. Elemental Zinc to Zinc Nanoparticles: Is ZnO NPs Crucial for Life? Synthesis, Toxicological, and Environmental Concerns. Nanotechnol. Rev. 2018, 7, 413–441. [Google Scholar] [CrossRef]
- Shao, S.; Chen, J.; Tang, H.; Ming, P.; Yang, J.; Zhu, W.; Zhang, S.; Qiu, J. A Titanium Surface Modified with Zinc-Containing Nanowires: Enhancing Biocompatibility and Antibacterial Property in Vitro. Appl. Surf. Sci. 2020, 515, 146107. [Google Scholar] [CrossRef]
- Wang, Y.; Wei, D.; Yu, J.; Di, S. Effects of Al2O3 Nano-Additive on Performance of Micro-Arc Oxidation Coatings Formed on AZ91D Mg Alloy. J. Mater. Sci. Technol. 2014, 30, 984–990. [Google Scholar] [CrossRef]
- Zhang, D.; Gou, Y.; Liu, Y.; Guo, X. A Composite Anodizing Coating Containing Superfine Al2O3 Particles on AZ31 Magnesium Alloy. Surf. Coat. Technol. 2013, 236, 52–57. [Google Scholar] [CrossRef]
- Arrabal, R.; Matykina, E.; Skeldon, P.; Thompson, G.E. Incorporation of Zirconia Particles into Coatings Formed on Magnesium by Plasma Electrolytic Oxidation. J. Mater. Sci. 2008, 43, 1532–1538. [Google Scholar] [CrossRef]
- Chaikina, M.V.; Bulina, N.V.; Vinokurova, O.B.; Prosanov, I.Y.; Dudina, D.V. Interaction of Calcium Phosphates with Calcium Oxide or Calcium Hydroxide during the “Soft” Mechanochemical Synthesis of Hydroxyapatite. Ceram. Int. 2019, 45, 16927–16933. [Google Scholar] [CrossRef]
- Korovin, M.S.; Fomenko, A.N. Antitumor Activity of Low-Dimensional Alumina Structures. AIP Conf. Proc. 2016, 1760, 020034. [Google Scholar] [CrossRef]
- Babayevska, N.; Przysiecka, Ł.; Iatsunskyi, I.; Nowaczyk, G.; Jarek, M.; Janiszewska, E.; Jurga, S. ZnO size and shape effect on antibacterial activity and cytotoxicity profile. Sci. Rep. 2022, 12, 8148. [Google Scholar] [CrossRef]
- Mendes, C.R.; Dilarri, G.; Forsan, C.F.; Sapata, V.d.M.R.; Lopes, P.R.M.; de Moraes, P.B.; Montagnolli, R.N.; Ferreira, H.; Bidoia, E.D. Antibacterial Action and Target Mechanisms of Zinc Oxide Nanoparticles against Bacterial Pathogens. Sci. Rep. 2022, 12, 2658. [Google Scholar] [CrossRef]
- Janotti, A.; Van de Walle, C.G. Fundamentals of Zinc Oxide as a Semiconductor. Rep. Prog. Phys. 2009, 72, 126501. [Google Scholar] [CrossRef]
- Alaya, L.; Saeedi, A.M.; Alsaigh, A.A.; Almalki, M.H.K.; Alonizan, N.H.; Hjiri, M. ZnO:V Nanoparticles with Enhanced Antimicrobial Activities. J. Compos. Sci. 2023, 7, 190. [Google Scholar] [CrossRef]
- Lallo da Silva, B.; Abuçafy, M.P.; Berbel Manaia, E.; Oshiro Junior, J.A.; Chiari-Andréo, B.G.; Pietro, R.C.R.; Chiavacci, L.A. Relationship Between Structure and Antimicrobial activity of Zinc Oxide Nanoparticles: An Overview. Int. J. Nanomed. 2019, 14, 9395–9410. [Google Scholar] [CrossRef] [PubMed]

| Elements | US Duration | |||||
|---|---|---|---|---|---|---|
| 10 | 20 | 30 | 40 | 50 | 60 | |
| Zn | 3 | 3 | 2 | 2 | 2 | 1 |
| O | 66 | 67 | 69 | 66 | 69 | 69 |
| P | 15 | 14 | 15 | 15 | 14 | 15 |
| Ca | 4 | 4 | 3 | 4 | 4 | 4 |
| Ti | 12 | 12 | 11 | 12 | 11 | 11 |
| Ca/P | 0.3 | 0.3 | 0.3 | 0.3 | 0.3 | 0.3 |
| Samples | Corrosion Potential (E), V | Corrosion Current Density (I), A/cm2 | Polarization Resistance (Rp), Ω·cm2 | Impedance Modulus (|Z|), Ω·cm2 |
|---|---|---|---|---|
| CP coatings | 0.12 | 2.5·10−9 | 2.4·106 | 3.7·106 |
| CP coatings with ZnO | 0.05 | 1.5·10−9 | 3.1·106 | 5.8·106 |
Disclaimer/Publisher’s Note: The statements, opinions and data contained in all publications are solely those of the individual author(s) and contributor(s) and not of MDPI and/or the editor(s). MDPI and/or the editor(s) disclaim responsibility for any injury to people or property resulting from any ideas, methods, instructions or products referred to in the content. |
© 2023 by the authors. Licensee MDPI, Basel, Switzerland. This article is an open access article distributed under the terms and conditions of the Creative Commons Attribution (CC BY) license (https://creativecommons.org/licenses/by/4.0/).
Share and Cite
Chebodaeva, V.; Sedelnikova, M.; Khimich, M.; Bakina, O.; Tolmachev, A.; Miller, A.; Golohvast, K.; Zakharenko, A.; Egorkin, V.; Vyaliy, I.; et al. Antibacterial Calcium Phosphate Coatings with Zinc Oxide Nanoparticles. Coatings 2023, 13, 1921. https://doi.org/10.3390/coatings13111921
Chebodaeva V, Sedelnikova M, Khimich M, Bakina O, Tolmachev A, Miller A, Golohvast K, Zakharenko A, Egorkin V, Vyaliy I, et al. Antibacterial Calcium Phosphate Coatings with Zinc Oxide Nanoparticles. Coatings. 2023; 13(11):1921. https://doi.org/10.3390/coatings13111921
Chicago/Turabian StyleChebodaeva, Valentina, Mariya Sedelnikova, Margarita Khimich, Olga Bakina, Alexey Tolmachev, Andrey Miller, Kirill Golohvast, Aleksander Zakharenko, Vladimir Egorkin, Igor Vyaliy, and et al. 2023. "Antibacterial Calcium Phosphate Coatings with Zinc Oxide Nanoparticles" Coatings 13, no. 11: 1921. https://doi.org/10.3390/coatings13111921
APA StyleChebodaeva, V., Sedelnikova, M., Khimich, M., Bakina, O., Tolmachev, A., Miller, A., Golohvast, K., Zakharenko, A., Egorkin, V., Vyaliy, I., & Sharkeev, Y. (2023). Antibacterial Calcium Phosphate Coatings with Zinc Oxide Nanoparticles. Coatings, 13(11), 1921. https://doi.org/10.3390/coatings13111921











